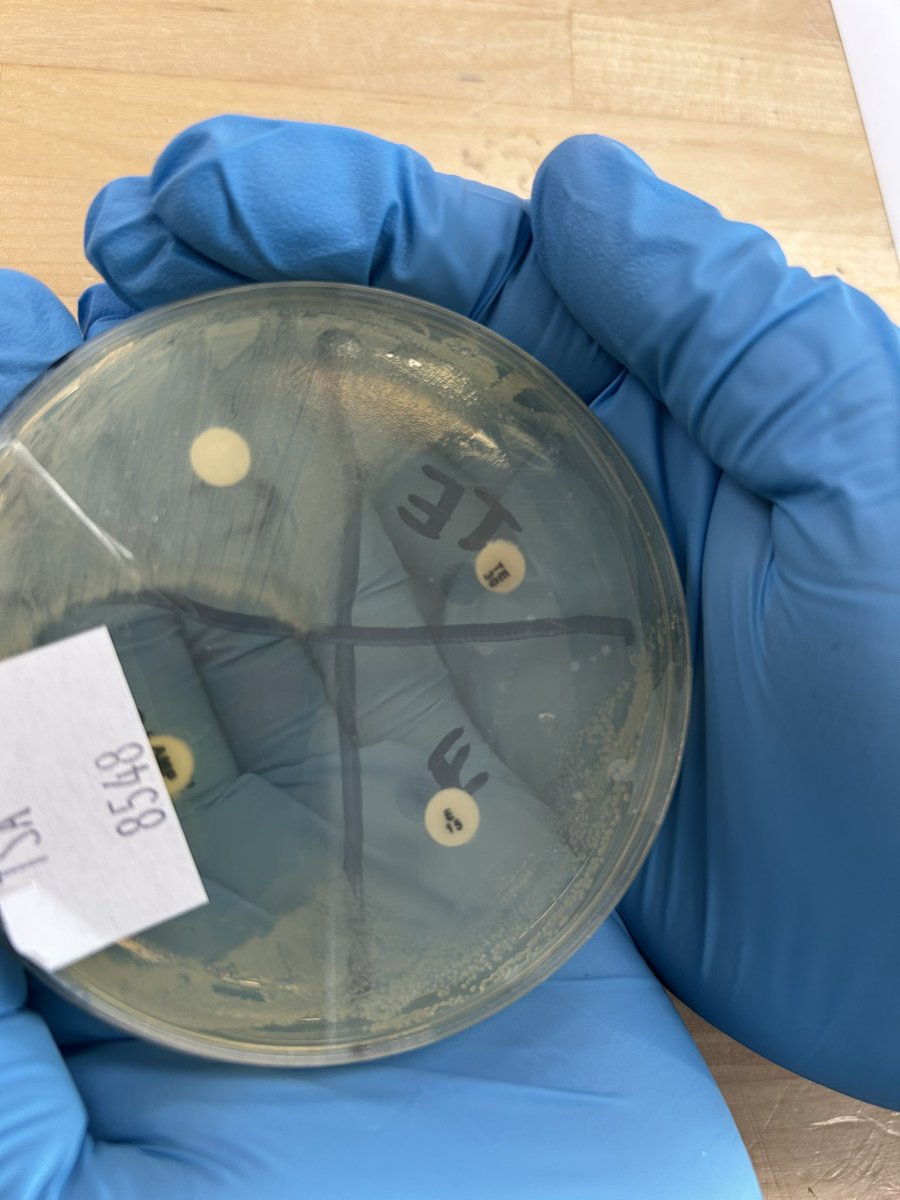
Testing antibiotics- such a cool experiment! 
<a href="/GreatOaksOhio/">Great Oaks Career Campuses</a> <a href="/PLTWorg/">Project Lead The Way</a>

MrsC’sPLTWClasses
@havroncl21
updates from Mrs Carroll’s PLTW classes at Harrison Jr. School- AC, MD, IM, ST, DM
ID: 80325574
06-10-2009 15:16:02
585 Tweet
74 Followers
128 Following

Medical detectives: learning how to take our vitals and recording data. PLTW Gateway MD is never boring! Great Oaks Career Campuses Project Lead The Way @harrisonjuniors


Activity 1.2- Experimental Design Lab- each group designed their own experiment that included a vital sign. Wildcat students demonstrated curriculum knowledge, leadership, ownership, and trust when completing this lab. Great Oaks Career Campuses Project Lead The Way

Testing antibiotics- such a cool experiment! Great Oaks Career Campuses Project Lead The Way

Plating bacteria and antibiotics to see which one will work best in killing the bacteria. Great Oaks Career Campuses Project Lead The Way



CSIM Project 1.5 Blinking Message projects/displays. Always so creative. Project Lead The Way Great Oaks Career Campuses


Modeling Neurons today in Medical Detectives. One of my favorite learning experiences in this class. Showing what you know. Great Oaks Career Campuses Project Lead The Way


So we changed up brain dissections and created a more focused exploration of the brain. Such an excellent modification to an already awesome lesson! Love when teachers share their ideas. Kids loved this activity. Great Oaks Career Campuses Project Lead The Way


Spooky Halloween houses created and coded so that 3 output devices were working inside the House. CSIM learning skills being utilized. #innovating and creating Project Lead The Way Great Oaks Career Campuses



Chemical Reactions- beginning the Unit with creating the best chemical reaction- Ice Cream anyone? PLTW Science of Technology Project Lead The Way Great Oaks Career Campuses

Innovators and Makers: Reaction Time game creation- PLTW- Great Oaks Career Campuses Project Lead The Way


Creating glue to create a volcano - this will be two chemical reactions in one project- PLTW Science of Technology Project Lead The Way Great Oaks Career Campuses


Buckyball creation in Science of Technology today. Great Oaks Career Campuses Project Lead The Way





Final results on which antibiotic worked the best. Project Lead The Way Great Oaks Career Campuses Great Oaks Satellites


3-D Models are taking shape in Medical Detectives today. Great Oaks Career Campuses Project Lead The Way



